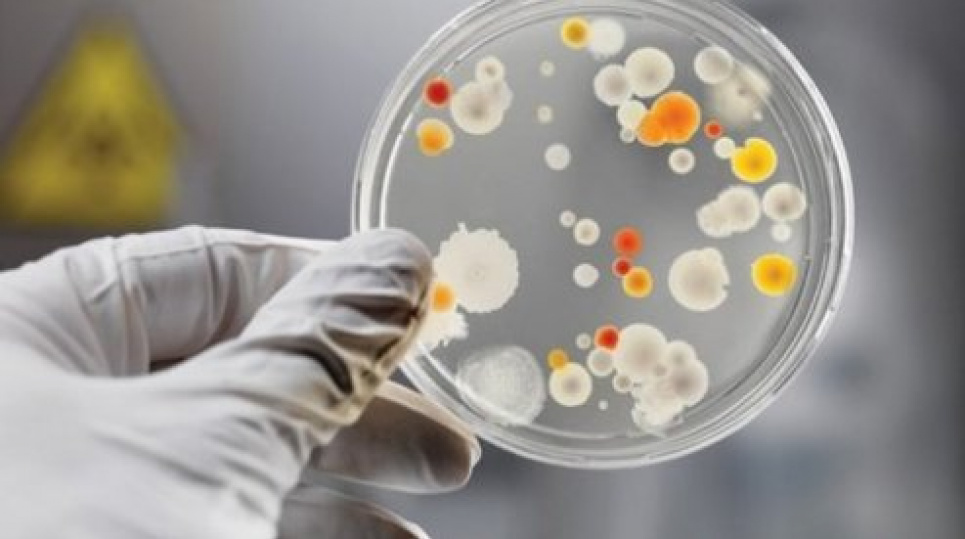

В Кропивницком вспышка лептоспироза
Жертвой стал мужчина среднего возраста.
30 июля стало известно о том, что в городе Кропивницком Кировоградской области мужчина заболел лептоспирозом и умер. Об этом сообщили в Кировоградском областном лабораторном центре.
Умерший — мужчина средних лет. Вероятно, заразился тогда, когда рыбачил на водоеме в Компанеевском районе. Человек мог наглотаться воды, в которой находились возбудители заболевания.
Это уже не первый случай смерти от опасной инфекции в области. В феврале 51-летний житель Кропивницкого заразился лептоспирозом и умер. Мужчина почувствовал себя плохо, но не спешил обращаться к врачам. В реанимацию городской больницы был доставлен уже в тяжелом состоянии. Спасти пациента медикам не удалось.
Лептоспироз — это острое инфекционное заболевание, которое поражает печень, почки и нервную систему. Возбудитель в организм человека попадает с некачественной водой. Переносят инфекцию крысы, собаки и крупный рогатый скот, которые выделяют лептоспиры с мочой.
Через две недели после инфицирования человек начинает жаловаться на сильную головную и мышечную боли, лихорадку. У больного краснеют глаза, а кожа и склеры желтеют, ведь возбудитель болезни поражает печень. Пациента с подозрением на лептоспироз необходимо немедленно изолировать от окружающих и начать интенсивное лечение.
Как писал GreenPost ранее, в Запорожье полицейские открыли уголовное производство по факту массового отравления людей, в частности, девятерых детей и пятерых взрослых, на базе отдыха в курортной Кирилловке.







